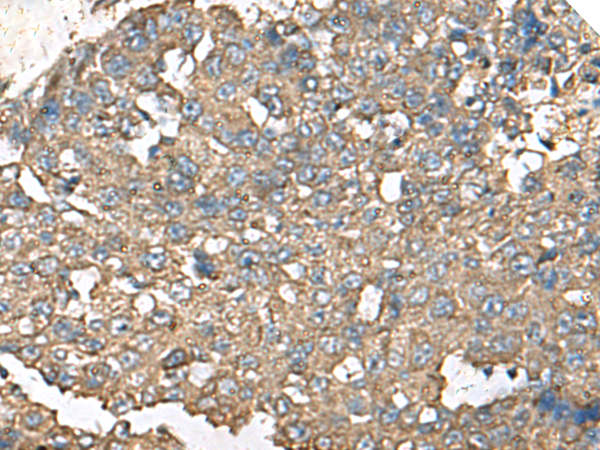

英文名稱: Anti-RPS14 rabbit polyclonal antibody
別 名: ribosomal protein S14; S14; EMTB
相關類別: 一抗
儲 存: 冷凍(-20℃)
宿 主: Rabbit
抗 原: RPS14
反應種屬: Human, Mouse, Rat
標記物: Unconjugate
克隆類型: rabbit polyclonal
Background:
Ribosomes, the organelles that catalyze protein synthesis, consist of a small 40S subunit and a large 60S subunit. Together these subunits are composed of 4 RNA species and approximately 80 structurally distinct proteins. This gene encodes a ribosomal protein that is a component of the 40S subunit. The protein belongs to the S11P family of ribosomal proteins. It is located in the cytoplasm. Transcript variants utilizing alternative transcription initiation sites have been described in the literature. As is typical for genes encoding ribosomal proteins, there are multiple processed pseudogenes of this gene dispersed through the genome. In Chinese hamster ovary cells, mutations in this gene can lead to resistance to emetine, a protein synthesis inhibitor. Multiple alternatively spliced transcript variants encoding the same protein have been found for this gene.
Applications:
ELISA, WB, IHC
Name of antibody:
RPS14
Immunogen:
Fusion protein of human RPS14
Full name:
ribosomal protein S14
Synonyms:
S14; EMTB
SwissProt:
P62263
ELISA Recommended dilution:
5000-10000
IHC positive control:
Human liver cancer and Human cervical cancer
IHC Recommend dilution:
50-200
WB Predicted band size:
16 kDa
WB Positive control:
231, HL60 and Jurkat cell lysates
WB Recommended dilution:
1000-5000
技術規(guī)格

購物車
幫助
021-54845833/15800441009
